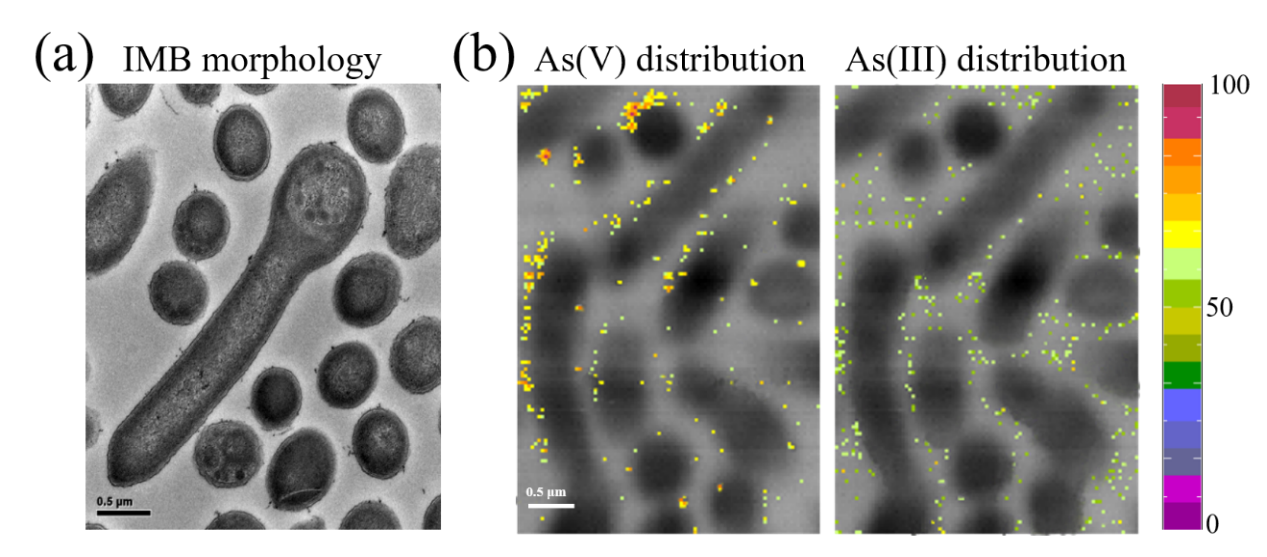

重要发现
山东大学叶丽博士、景传勇教授、西北农林科技大学田海霞副教授与上海光源软X射线谱学显微线站(BL08U1A)合作,利用同步辐射X射线显微成像(STXM)和原位X射线吸收精细结构谱(in situ XAFS)技术对典型砷还原菌Alkaliphilus sp. IMB的砷还原过程进行了原位观测,发现IMB还原五价砷(As(V))的过程发生在细胞膜上。
研究的重要性和影响力
砷还原菌(AsRB)是导致砷释放的重要环境媒介,该工作为表征微生物原位氧化还原金属污染物过程提供了新的思路。相关成果以“Arsenic mobilization in nZVI residue by Alkaliphilus sp. IMB: Comparison between static and flowing incubation”为题,于2023年发表在《环境污染》(Environmental pollution)上。
研究背景
砷还原菌(AsRB)被认为是导致砷释放的重要环境媒介,其通过将As(V)还原为迁移性更强的三价砷(As(III))促进砷从固相释放至水体。但有些研究却发现AsRB并未促进砷的释放。此矛盾核心在于还原的As(III)是否可以被含铁矿物再次吸附。前期研究常在封闭静态体系开展实验,聚焦于二次铁矿对As(III)吸附能力的强弱,忽视了As(III)再吸附速率。研究组认为As(V)的还原速率与As(III)再吸附速率的差异可能是评估AsRB对吸附态砷迁移释放作用的关键。
主要研究内容
为证实此科学假设,本研究从砷污染沉积物中分离得到一株砷还原菌IMB,并根据16S rRNA分析得知其为Alkaliphilus属。IMB具有砷还原基因arrA,当其与1 mM As(V)共培养时,可在120小时内将约80%的As(V)还原为As(III)。运用同步辐射扫描透射 X 射线显微技术(STXM)对其As(V)还原过程进行原位表征,发现溶解态As(V)附着于细胞表面,而还原产物As(III)分散在细胞周边。此结果表明IMB还原As(V)的过程发生在细胞外膜。之前为研究As(V)还原酶在细胞中的位置,需通过传统生物学手段将细胞各部分分离,操作复杂费时。本研究中将STXM用于表征细胞中砷形态分布情况,清晰明了且操作简便。
为进一步研究As(III)再吸附速率对砷迁移释放的影响,开展了静态与原位流动两组实验。在封闭静态培养实验中,将IMB与吸附了砷的零价纳米铁废泥(nZVI)共培养,水化学和As K边X射线吸收近边结构光谱(XANES)结果发现静态实验中IMB还原产物As(III)再吸附至固相,因而As(V)还原并未促进砷的释放。与静态实验形成鲜明对比的是,在原位流动培养实验中,IMB极大地促进了砷的释放。在原位流动条件下,IMB极大促进砷释放的根本原因是溶解态As(III)再吸附过程被抑制。IMB可在约1小时的短暂时间将溶解态As(V)完全还原为As(III),但还原产物As(III)却不能迅速再吸附至固相,而是随着水流流出。
图1.(a)透射电子显微镜表征Alkaliphilus sp. IMB形貌;(b)STXM表征IMB与As(V)共培养后,As(V)与As(III)的分布特征。
展望
静态培养实验条件类似环境中的湖泊水库等,而原位流动实验条件则类似地下水情况。本文提出As(V)还原速率与As(III)再吸附速率差异是影响AsRB迁移释放砷的关键,并推测AsRB在静态环境对砷释放影响可能不大,而在流动水体环境可能会显著促进砷释放。该研究为表征微生物原位氧化还原金属污染物过程提供了新的思路。
联系人
BL08U1A用户负责人:许子健,xuzj@sari.ac.cn, 13681612583
相关论文
Li Ye, Haixia Tian, Chuanyong Jing,* Arsenic mobilization in nZVI residue by Alkaliphilus sp. IMB: Comparison between static and flowing incubation. Environmental Pollution 319, 121019 (2023).
附件下载:
